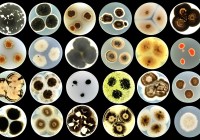
Credits: Ana Gubenšek

Gegen Pilze und Borkenkäfer: Eine Mischung aus Monoterpenen ist vielversprechend
Die Fichte (Picea abies), die über viele Jahrzehnte hinweg der „Brotbaum“ der Holzwirtschaft war, ist durch jahrelange Trockenheit und hohe Temperaturen geschwächt. Der Anbau in Monokultur verschärfte das Problem: Der Große Achtzähnige Fichtenborkenkäfer (Ips typographus), auch Buchdrucker genannt, hatte leichtes Spiel. Der etwa vier bis fünf Millimeter lange Käfer verrichtet sein Zerstörungswerk jedoch nicht allein, sondern gemeinsam mit… Weiterlesen »